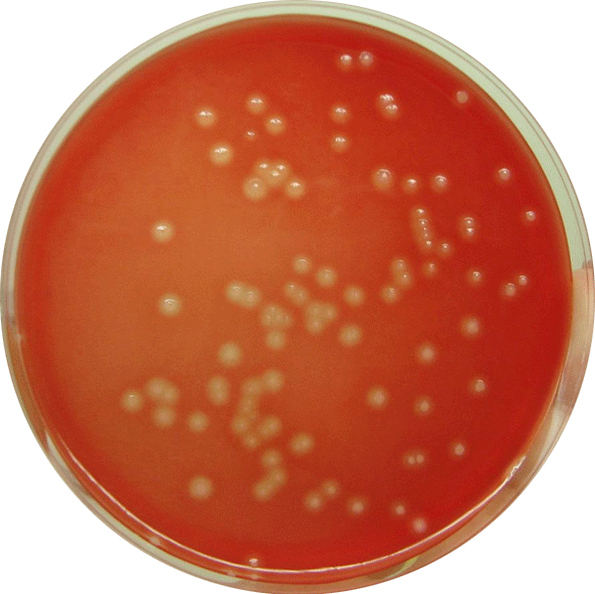
Beta-hemolytic colonies of Streptococcus agalactiae - Beta-hemolytic colonies ofS. agalactiae(Image source: wikimedia.org)

*Streptococcus agalactiae,*also known as Group B Streptococcus (GBS), is a major cause of neonatal sepsis and meningitis. Other infections caused by Group B Streptococci include postpartum endometritis and bacteremia among pregnant women and pneumonia, endocarditis, skin and soft tissue infections, etc.,**in adults with underlying diseases.

General Properties
- Gram-positive cocci in pairs and chains
- Capsulated: S. agalactiaehas 10 distinct serotypes including nine capsular serotypes; Ia, Ib, and II to VIII and one nontypeable strain (serotype IX)
- Facultative anaerobic
- Non-sporing
Pathogenesis
Virulence FactorsofStreptococcus agalactiae
- **Polysaccharide capsular antigens:**Inhibits activation of the alternative complement cascade and prevents phagocytosis
- **C5a peptidase:**C5a peptidase produced by the streptococci cleave complement componentC5a and interfere with C5a-mediated neutrophil chemotaxis. This peptidase also binds to fibronectin and serves as a bacterial adhesin and invasin
- **Beta-hemolysin/cytolysin:**Pore-forming hemolysin that is able to lyse pulmonary alveolar epithelial and endothelial cells and plays a role in neonatal lung infection and subsequent sepsis.
- **Lipoteichoic acid:**Participate in facilitating adherence as the first step in infection.
- Cell surface proteins:
C antigen:
May mediate internalization of organisms within human cervical epithelial cells following attachment. Protect organisms from intracellular killing following phagocytosis
**Cell surface penicillin-binding protein (PBP 1a):**Enables streptococcal cells to resist intracellular killing by phagocytic cells. **Hyaluronic acid lyase:**This may act to spread infection by the breakdown of hyaluronic acid in the extracellular matrix, and may act on the hyaluronic acid present in concentrations in placental tissues, fetal tissues, and amniotic fluids.
Disease & Clinical PresentationofStreptococcus agalactiae
Rectovaginal colonization of Streptococcus agalactiae is found in 10% to 37% of pregnant women which may be transient, intermittent, or persistent. The presence of group B streptococci in the female genital tract at the time of birth can lead to infection of the neonate. Streptococcus agalactiae is a predominant cause of acute meningitis in neonates.
Predisposing factors for neonatal infection with S. agalactiae are;
- rupture of membranes more than 18 hours before delivery
- labor prior to 37 weeks (infant is premature)
- absence of maternal antibody, and
- heavy colonization of the genital tract by S. agalactiae
Neonatal disease with group B streptococci follows two patterns, termed early-onset disease and late-onset disease.
- Early-onset disease:
is associated with in utero or perinatal (during passage through a birth canal that is colonized with group B streptococci) organism acquisition. Onset of disease occurs within 12 hours to 5 days after birth. The disease spectrum includes bacteremia, pneumonia, meningitis, septic shock, and neutropenia.
- Late-onset-disease:
acquired from the birth canal of colonized mothers or from postnatal acquisition from the mother, other caregivers, or nosocomially Onset of disease occurs within 7 days to 3 months (average 3 to 4 weeks) after birth. Bacteremia is the predominant clinical presentation, and about 25% of these infants also develop group B streptococcal meningitis.
Laboratory diagnosis
Specimen Collection
- Detection of carriers(i.e. perinatal detection of GBS): One vaginal and one rectal swab, collected and sent in Amies of Stuart’s medium without charcoal, within 4 hours of sample collection.
- **Diagnosis of cases:**CSF, blood and other samples (depending on clinical presentations).
Enrichment broth: Todd-Hewitt broth with antimicrobials (gentamicin, nalidixic acid, or colistin) is used to suppress the growth of vaginal flora and allow the growth ofS. agalactiae.
The presence of Gram-positive cocci in short chains in the CSF of neonates is presumptively identified asStreptococcus agalactiae.
A: Culture
Culture media: Blood Agar
Isolation ofStreptococcus agalactiaefrom a genital site of a woman at term should be communicated as an urgent report.
Colony characteristics inblood agar*:*Colonies are larger than group A streptococci; translucent to opaque; flat, glossy; narrow zone of beta-hemolysis. Some strains are non-hemolytic.
Test for the identification of suspected GBS (S. agalactiae) colonies
- **Catalase test:**When we observe beta-hemoytic colonies in blood agar, performing catalase test, helps to differentiate between beta-hemolytic streptococci from staphylococci. Staphylococci are catalase-positive whereas streptococci are catalase-negative.

-
CAMP test:CAMP test may be employed for presumptive identification of catalase-negative, beta-hemolytic streptococci. S. agalactiaegives enhanced arrowhead beta-hemolysis at the juncture of S.agalactiae and S. aureusstreaks; when streaked at perpendicular with beta-hemolytic S. aureus in blood agar.
-
**Bacitracin resistant:**Bacitracin sensitivity test helps to differentiate between two beta-hemolytic streptococci; Streptococcus pyogenes (GAS)and Streptococcus agalactiae(GBS). GAS is bacitracin sensitive whereas GBS is bacitracin resistant.
Biochemical Tests
Following biochemical tests are useful for the identification of S. agalactiae.
| Name of the test | S. agalactiae | Notes |
|---|---|---|
| Catalase test | Negative | Streptococci are catalase-negative, whereas staphylococci are catalase positive. |
| Hemolysis | β-hemolysis | |
| CAMP test | Positive (enhanced arrowhead hemolysis) | Presumptive identification of Group B beta-hemolytic streptococci |
| Pyrrolidonyl-β-naphthylamide (PYR) test | Negative | Streptococcus pyogenes is PYR positive. |
| Bacitracin sensitivity test | Resistant | S. pyogenes , the other β-hemolytic streptococci are bacitracin sensitive. |
| Hippurate hydrolysis test | Positive | Differentiation of β-hemolytic Streptococcus agalactiae from other β-hemolytic streptococci. |
B: Other tests
- Latex agglutination: Several commercial antigen detection kits are available for diagnosis of neonatal sepsis and meningitis using serum CSF or urine as a sample.
- DNA probe, nucleic acid amplification test (NAAT), or other molecular testing are also available for the identification of S. agalactiae.
References and further readings
- Procop, G. W., & Koneman, E. W. (2016). Koneman’s Color Atlas and Textbook of Diagnostic Microbiology (Seventh, International edition). Lippincott Williams and Wilkins.
- Teatero, S., Ferrieri, P., Martin, I., Demczuk, W., McGeer, A., & Fittipaldi, N. (2017). Serotype Distribution, Population Structure, and Antimicrobial Resistance of Group B Streptococcus Strains Recovered from Colonized Pregnant Women. Journal of Clinical Microbiology, 55(2), 412–422.
- Tille, P. (2017). Bailey & Scott’s Diagnostic Microbiology(14 edition). Mosby.
- Raabe, V. N., & Shane, A. L. (2019). Group B Streptococcus (Streptococcus agalactiae). Microbiology Spectrum, 7(2).